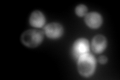
YJL052W

View description
Glyceraldehyde-3-phosphate dehydrogenase, isozyme 1, involved in glycolysis and gluconeogenesis; tetramer that catalyzes the reaction of glyceraldehyde-3-phosphate to 1,3 bis-phosphoglycerate; detected in the cytoplasm and cell wall
Localization:
Intensity:
Fold change:
Significance:
-
C’ GFP library in SD

cytosol1698.56 -
N' NOP1pr-GFP in SD

cytosol516.838 -
N' TEF2pr-mCherry in SD

cytosol542.419 -
N' NATIVEpr-GFP in SD

cytosol,nucleus822.871 -
N' TEF2pr-VC and Cyto-VN in SD

cytosol93.034 -
C’ GFP library in SD+DTT

cytosol2851.581.67Yes -
C’ GFP library in SD+H2O2
cytosol1579.70.93No -
C’ GFP library in Starvation Media

cytosol2161.061.27No -
C’ GFP library on the background of Pup2-DaMP

cytosol -
C’ GFP library on the background of CCT mutant

cytosol1937.761.14082No
